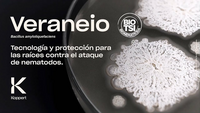

Aplicación
NÚMERO, TIEMPO E INTERVALO DE APLICACIÓN: al tratar las semillas con el producto VERANEIO se debe realizar una única aplicación. Utilice la dosis más alta
en regiones con antecedentes de nematodos y/o en condiciones más favorables para desarrollo de estos objetivos (historial de altas presiones, altas temperaturas y altas precipitaciones). Las dosis más bajas deben utilizarse en lugares de menor presión y/o condiciones climáticas menos favorables para el desarrollo de la plaga.
APLICACIÓN: tratamiento de semillas (preemergente): agitar enérgicamente el producto en su envase original. El producto puede mezclarse con agua, haciendo
un total máximo de 600 mL de jarabe para tratar 100 kg de semillas.
MÉTODO DE APLICACIÓN, EQUIPOS DE APLICACIÓN, ESTRATEGIAS DE USO:
El producto se aplica a través del tratamiento de semillas utilizando equipos de mezcla como hormigoneras o tambores rotativos normalmente adaptados para este fin, con el fin de mantener la seguridad en la aplicación y la cobertura uniforme de las semillas.
Tras el tratamiento, las semillas deben almacenarse en lugares frescos y secos y libres de la luz solar directa.
La preparación de la solución VERANEIO debe diluirse en agua limpia, en la proporción 1:1 siguiendo los parámetros más indicados para cada cultivo y no debe superar el límite máximo recomendado, evitando así dañar la semilla.